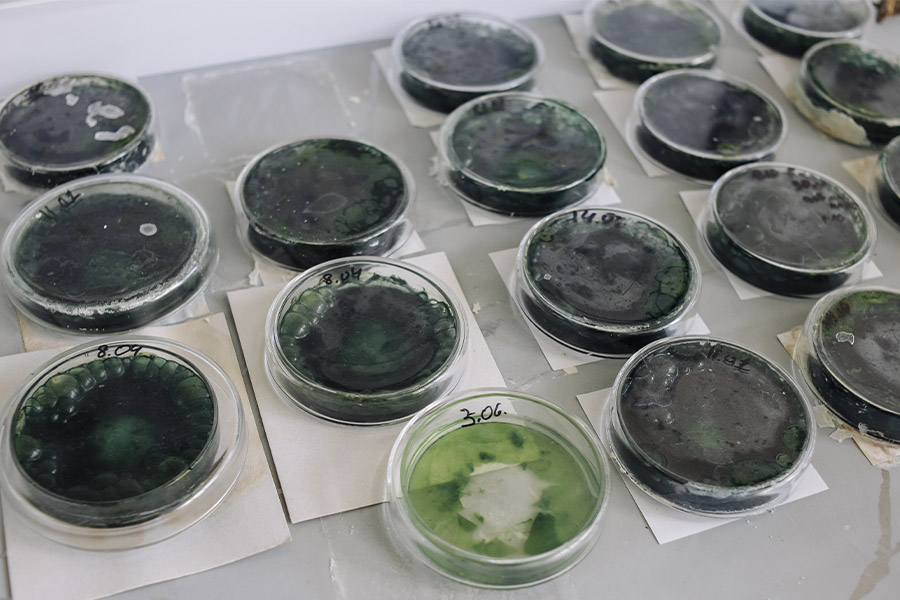

- Новости
- В политехе разрабатывают инновационные сладости, полезные для организма
В политехе разрабатывают инновационные сладости, полезные для организма
Студентка художественно-технологического факультета ОмГТУ Анастасия Полякова создает линейку кондитерских изделий на основе микроводросли Limnospira Fusiformis. Продукты сохраняют вкус классических десертов, становясь при этом источником полезных для человеческого организма веществ и предотвращая различные заболевания. Проект одержал победу в конкурсе «Студенческий стартап» – на его развитие выделен 1 миллион рублей.

Нативные микронутриенты – это естественные вещества, которые присутствуют в пищевых продуктах. Они нужны человеку в очень малых количествах для поддержания здоровья и нормального функционирования. К ним относятся витамины, минералы, аминокислоты и другие соединения, которые организм не всегда способен синтезировать самостоятельно и должен получать с пищей.
Научным руководителем исследования выступает профессор кафедры «Биотехнология, технология общественного питания и товароведение» Елена Молибога. Политехники разрабатывают кондитерские изделия (маршмеллоу, пастилу, мармелад), насыщенные жизненно важными микронутриентами растительного и микробиологического происхождения. Для этого используется сине-зеленая нитчатая микроводоросль Limnospira Fusiformis. Привычные сладости в трансформированном виде сохраняют свой вкус, запах и текстуру, но их пищевая и биологическая ценность повышается. Продукты с улучшенными полезными свойствами помогают компенсировать дефицит витаминов, антиоксидантов и белков, поддерживают иммунитет, способствуют профилактике различных заболеваний, связанных с несбалансированным питанием.
Этапы исследования следующие: это разработка рецептур кондитерских изделий различной направленности, оптимизация содержания микронутриентов и тестирование их усвояемости в организме человека. Также по условиям гранта мы нацелены на создание технологического производства и коммерциализацию функциональных продуктов, ориентированных на здоровое питание и профилактику заболеваний, связанных с несбалансированным питанием.
|
Анастасия Полякова, студентка художественно-технологического факультета ОмГТУ: Кроме того, грант открывает дополнительные возможности для привлечения партнеров и инвесторов. Я надеюсь, что нам удастся создать устойчивый и успешный проект с долгосрочным социальным и экономическим эффектом». |
На грантовые средства будет закуплено оборудование и необходимые реактивы, также средства пойдут на подготовку лабораторных образцов, оформление патентной документации, проведение маркетинговых мероприятий.
Напомним, Анастасия уже получала гранты на свои исследования, связанные со спирулиной. Текущий проект реализуется при поддержке Фонда содействия инновациям в рамках программы «Студенческий стартап» федерального проекта «Платформа университетского технологического предпринимательства», входящего в нацпроект «Эффективная и конкурентная экономика». Также исследование проводится в рамках Десятилетия науки и технологий и является участником Акселерационной программы «РОСТ» 2025 года на базе ОмГТУ, проводимого в рамках федерального проекта «Технологии» нацпроекта «Эффективная и конкурентная экономика».